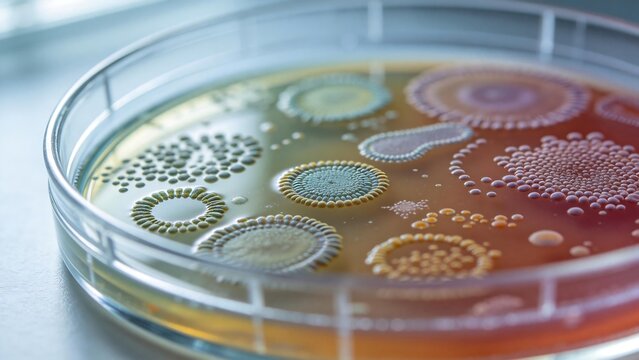
Petri dish with bacterial colonies

새 필터 추가됨
정렬 기준
지역 선택
지역을 선택하면 Adobe Stock 웹 사이트에 표시되는 언어와 프로모션 내용이 변경될 수 있습니다.
북아메리카
남아메리카
- Venezuela
- Algeria - English
- Armenia - English
- Azerbaijan - English
- Bahrain - English
- Belgium - English
- Belgique - Français
- België - Nederlands
- Česká republika
- Croatia - English
- Cyprus - English
- Danmark
- Georgia - English
- Deutschland
- Eesti
- Egypt - English
- España
- France
- Greece - English
- Iceland - English
- Ireland
유럽, 중동 및 아프리카
- Israel - English
- Italia
- Jordan - English
- Казахстан
- Kenya - English
- Kuwait - English
- Киргизия
- Latvija
- Lebanon - English
- Lietuva
- Luxembourg - Deutsch
- Luxembourg - English
- Luxembourg - Français
- Mauritius - English
- Moldova - English
- Hungary - English
- Malta - English
- Morocco - English
- Nederland
- Nigeria
- Norge
- Oman - English